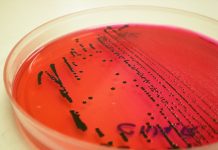

Quando si parla di parassitosi intestinali non si può non parlare dei vermi neri nelle feci che si possono trovare sia negli adulti che nei bambini.
I vermi in questione sono gli ascaridi, dei vermi più scuri rispetto agli ossiuri e talvolta sono visibili nelle feci anche ad occhio nudo.
Sono dei vermi tondi che causano una parassitosi insediandosi e proliferando nell’intestino di uomo e animali causando una patologia che prende il nome di ascaridiasi.
Nel corso di questa guida ti parlerò delle caratteristiche degli ascaridi, del loro ciclo vitale, dei sintomi della patologia intestinale che provocano. Ti parlerò anche delle analisi che bisogna fare per diagnosticare ed identificare i vermi neri infettanti, la terapia farmacologica e tutte le misure per evitare il contagio.
In questo articolo parliamo di:
Ascaridi: cosa sono? come si trasmettono?
Gli ascaridi sono dei vermi neri molto sottili che possono arrivare ad una lunghezza di 30 centimetri negli esemplari femminili e di 20 in quelli maschili. Il nome scientifico è Ascaris lumbricoides e sono dei parassiti abbastanza diffusi nelle zone tropicali, dove oltre ai bambini, che rappresentano comunque gli ospiti preferiti, questi vermi infettano anche gli adulti in misura maggiore rispetto a quello che succede nei paesi a clima temperato.
Giocano un ruolo importante nella trasmissione di questa parassitosi anche le condizioni igieniche precarie.
Questi vermi neri non hanno bisogno di un ospite intermedio per infettare l’uomo o altri animali. La trasmissione è oro fecale, ossia gli ascaridi depongono le loro uova nell’intestino del soggetto colpito dall’infestazione. Vengono disseminate nell’ambiente circostante in massima parte grazie alle feci.

Una volta ingerite le uova si schiudono liberando delle larve che iniziano a svilupparsi anche dal punto di vista riproduttivo per poi diffondersi anche in altri organismi.
Prima di arrivare all’esemplare adulto dovranno trascorrere due settimane dal contagio. Una femmina adulta in un solo giorno può deporre migliaia di uova che vengono rilasciate all’esterno, dove riescono a sopravvivere per molto tempo, specie in condizioni igieniche precarie e in climi caldi e umidi.
Una volta ingerite le uova impiegano dai 10 giorni alle due settimane per schiudersi e iniziare un ciclo vitale nel nuovo ospite.
Quali sono i sintomi della ascaridiosi?
Gli ascaridi, ovvero i vermi neri della guida di oggi, danno luogo ad una parassitosi caratterizzata da sintomi abbastanza variegati, ma nella maggior parte dei casi si presenta con un decorso completamente asintomatico. Talvolta possono comparire subito dei disturbi o arrivare dopo qualche settimana.
I sintomi immediati, quando compaiono, interessano le vie aeree superiori e si manifestano con tosse, gola secca, fatica a respirare. Vi spiego il perché.
Quando le uova ingerite si schiudono nell’intestino, le larve attraversano la parete intestinale e arrivano al torrente circolatorio, attraverso il quale raggiungono le vie aeree per poi essere deglutite e arrivare all’intestino nella loro forma adulta. Si può dire quindi che la maturazione degli ascaridi si compie in giro per l’organismo. Questo spiega perché, se ci sono dei sintomi nella fase iniziale, questi interessano l’apparato respiratorio e non l’intestino.
I sintomi che sopraggiungono dopo il periodo di incubazione interessano esclusivamente il tratto intestinale, e sono molto comuni ad altri tipi di parassitosi o altre patologie intestinali. Si presenta diarrea persistente, dolori, crampi addominali, nausea e vomito.
Diagnosi
Quando si osservano questi sintomi non bisogna mai procedere con l’automedicazione in quanto si rischia di creare ulteriori danni. La prima cosa da fare è quella di contattare subito il medico o il pediatra in modo da riferire tutti i disturbi e consentirgli di procedere ad una diagnosi per stabilire la giusta cura.
Spesso all’interno delle feci sono visibili dei vermi neri vivi che si muovono ed è questo il fenomeno che allarma le mamme e le spinge a contattare il pediatra, il quale dopo una attenta anamnesi consiglierà un esame parassitologico per identificare il verme.
Trattamento
Abbiamo a disposizione diversi farmaci antielmintici per il trattamento dell’ascaridiasi, che sono gli stessi usati anche nell’ossiuriasi. Lo schema terapeutico consiste nella somministrazione di un farmaco antielmintico in una dose unica, da ripetere nello stesso modo dopo due settimane, tempo in cui le eventuali uova, sulle quali questi farmaci non hanno nessun effetto, impiegano a schiudersi.
Al trattamento vengono sottoposti anche i familiari e chiunque sia stato in contatto con il paziente, ma non perché è possibile un contagio tra individui, ma in quanto le uova si concentrano nei tessuti, sugli oggetti e in tutto l’ambiente condiviso da più soggetti.
I farmaci in questione sono:
- Vermox® il cui principio attivo è il mebendazolo. Si tratta di un farmaco ben tollerato in quanto viene assorbita solo una minima parte della dose somministrata, e di questa quasi tutta viene legata dalle proteine plasmatiche e metabolizzata rapidamente a metaboliti inattivi ad opera del fegato. L’assorbimento però, aumenta se la somministrazione è accompagnata da un pasto ricco di grassi, diminuendo la quantità di mebendazolo che agisce nell’intestino sui parassiti. Ecco perché è conveniente somministrarlo lontano dal pasto. Inoltre, l’efficacia del farmaco è legata al tempo di transito intestinale ed all’entità dell’infestazione.
Il dosaggio va aggiustato in base al peso del bambino per il quale il farmaco viene formulato in soluzione orale, mentre per gli adulti è presente in compresse.
- Combantrin®, il cui principio attivo è il pirantel pamoato. Si tratta di un antielmintico ad ampio spettro, che agisce paralizzando il verme fino alla morte.
- Zentel®, il cui principio attivo è l’albendazolo. Si tratta di un farmaco ad ampio spettro, infatti viene impiegato anche in altri tipi di parassitosi oltre che nell’ascaridiasi.
Naturalmente sarà il medico a decidere quale farmaco sia più opportuno al singolo caso. Va ricordato che gli ossiuri sono dei parassiti e non dei batteri, per cui gli antibiotici non sono assolutamente efficaci.
Come prevenirli?
Come già specificato, per gli ascaridi, così come per tutti i parassiti intestinali, le condizioni igieniche sono davvero molto importanti. Siccome spesso le uova si concentrano sulle mani, ed in particolar modo sotto le unghie, è sempre buona abitudine lavare le mani prima di portarle sui cibi, lavare frutta e verdura, specie se consumate crude, evitando di consumare pietanze non cotte soprattutto quando si viaggia.
Inoltre, una volta accertata l’ascaridiosi in un bambino vanno avvertite le strutture frequentate da quest’ultimo, in modo che i genitori di tutti i bambini che sono stati a contatto possano far sottoporre i propri figli a dei controlli per scoprire se sono stati contagiati e, in caso affermativo iniziare subito una cura, indirizzati naturalmente dal loro medico.
Condividi su: